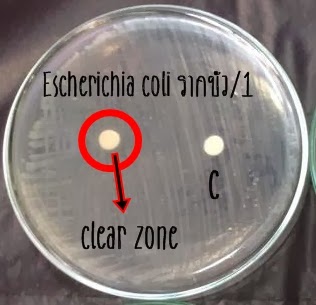

เทคนิคพื้นฐานทางจุลชีววิทยา
1. บทนำ
ในการเรียนวิชาทางจุลชีววิทยาสิ่งที่ขาดไม่ได้ คือ บทปฏิบัติการที่มีไว้เพื่อให้ได้รู้หลักการและฝึกหัดเทคนิคพื้นฐานในการทำปฏิบัติการทางจุลชีววิทยาอย่างถูกวิธี เพราะงานทางจุลชีววิทยาต้องการความสะอาดและปลอดภัยเป็นอย่างสูง ดังนั้น การฝึกเทคนิคพื้นฐาน เช่น การแยกเชื้อบริสุทธิ์ (isolation of pure culture) และการถ่ายเชื้อ (culture transfer) นอกจากจะฝึกให้สามารถแยกเชื้อและถ่ายเชื้อเป็นแล้ว ยังมีวัตถุประสงค์เพื่อให้รู้จักการหลีกเลี่ยงไม่ให้เกิดการปนเปื้อน (contamination) ของเชื้ออื่นที่ไม่ต้องการจากสภาพแวดล้อมที่กำลังทำการทดลอง การทำปฏิบัติการทางจุลชีววิทยาจึงมีจำเป็นที่ต้องใช้อุปกรณ์หรือเครื่องมือบางอย่างที่จำเพาะ เพื่อใช้ในการฆ่าเชื้อและการเลี้ยงเชื้อ ดังนั้นจึงต้องทราบถึงหลักปฏิบัติการทางจุลชีววิทยา และวิธีการใช้งานเครื่องมือพื้นฐานทางจุลชีววิทยาอย่างถูกต้องและเคร่งครัด เพื่อความปลอดภัยของตัวเองและผู้อื่น
2. เทคนิคที่ใช้ในการแยกเชื้อบริสุทธิ์
2.1 Spread-Plate Technique
ในแหล่งธรรมชาตินั้นปกติเชื้อแบคทีเรียจะเติบโตอยู่รวมกันหลายๆสายพันธุ์ เพื่อการคัดแยกและจำแนกชนิดของแบคทีเรียแต่ละสายพันธุ์จะต้องมีขั้นตอนการทำให้เชื้อบริสุทธิ์ (pure culture) โดยเทคนิคที่ทำได้ง่ายคือ spread plate technique ซึ่งเทคนิคนี้แบคทีเรียที่ถูกทำให้เจือจางให้มีจำนวนประมาณ 100-200 เซลล์ หรือน้อยกว่าจะถูกนำไปวางตำแหน่งตรงกลางของจานเพาะเชื้อ (petri dish/plate) แล้วทำการเกลี่ยให้เชื้อกระจายทั่วด้วยแท่งแก้วรูปตัว L หลังจากบ่มที่อุณหภูมิที่เหมาะสมและมีระยะเวลาเพียงพอ จะปรากฏโคโลนี (colony) ของเชื้อแบคทีเรียขึ้น โดยแต่ละโคโลนีจะมีจำนวนแบคทีเรียอยู่จำนวนมาก และแต่ละโคโลนีจะถือว่ามาจากแบคทีเรียสายพันธุ์เดียว ดังนั้นจะทำให้เกิดการแยกจุลินทรีย์ออกมาเป็นเชื้อบริสุทธิ์ขึ้น เมื่อมองด้วยตาเปล่าแบคทีเรียแต่ละสายพันธุ์โคโลนีจะมีลักษณะแตกต่างกันดังแสดงในภาพที่ 1-1 นอกจากนั้นยังสามารถทำให้เชื้อมีความบริสุทธิ์มากขึ้นโดยการนำโคโลนีที่ต้องการไปเพาะเลี้ยงในจานเพาะเชื้อที่มีอาหารใหม่ด้วยเทคนิคที่เรียกว่า Streak-Plate Technique
ภาพที่ 1-1 ลักษณะโคโลนีของแบคทีเรียที่เจริญบนอาหารแข็งและคำ (Key word) ที่ใช้ในการอธิบายลักษณะโคโลนี
ที่มา: Prescott (2002)
2.2 Pour Plate Technique
เทคนิคการเพาะเชื้อแบบ pour-plate technique ก็เป็นอีกวิธีการหนึ่งที่ใช้ในการแยกเชื้อให้บริสุทธิ์ได้เช่นกัน โดยตัวอย่างเริ่มต้นจะถูกเจือจางให้มีความเข้มข้นหลายๆ ระดับด้วยเทคนิค serial dilution เพื่อทำให้เชื้อถูกเจือจางมากพอที่จะทำให้เกิดโคโลนีเดี่ยวๆ บนจานเพาะเชื้อ โดยนำตัวอย่างที่มีความเข้มข้นที่เหมาะสมเติมลงในจานเพาะเชื้อเปล่าที่ผ่านการฆ่าเชื้อแล้ว แล้วทำการเทอาหารวุ้นลง (Agar Medium) ไปในจานเพาะเชื้อ (โดยอุณหภูมิของอาหารเพาะเชื้อประมาณ 48-50 องศาเซลเซียส ซึ่งจะไม่ทำให้เชื้อแบคทีเรียและยีสต์ตายได้) ผสมอาหารและเชื้อให้เข้ากันและให้เกิดการกระจายอย่างสม่ำเสมอด้วยการหมุนจานเพาะเชื้อ เมื่อวุ้นเกิดการแข็งตัว เซลล์จุลินทรีย์จะถูกตรึงให้อยู่ด้านในของอาหาร และจะเกิดโคโลนีเดี่ยวๆ ของเชื้อขึ้นมา
2.3 Streak-Plate Technique
การแยกเชื้อให้บริสุทธิ์เป็นเทคนิคพื้นฐานทางจุลชีววิทยาที่มีความสำคัญอย่างมาก เนื่องจากสิ่งแวดล้อมต่างๆ เช่น น้ำ อากาศ พื้นห้องเรียน หรือแม้แต่ร่างกายของคนก็มีเชื้อจุลินทรีย์อยู่หลายชนิดที่อาจปนเปื้อนในหลอดเพาะเชื้อได้ หลักการของการแยกเชื้อให้บริสุทธิ์บนอาหารเลี้ยงเชื้อ (culture medium) คือ จะต้องแยกเชื้อให้ได้โคโลนีเดี่ยวๆ (single colony) จำนวนมาก จากนั้นจึงนำเชื้อที่เป็นโคโลนีเดี่ยวไปศึกษารูปร่างลักษณะ และคุณสมบัติต่างๆ เพื่อให้ทราบว่าเป็นเชื้อชนิดใด เทคนิคที่นิยมใช้ในการแยกเชื้อบริสุทธิ์คือ วิธี cross streak plate ซึ่งทำได้โดยใช้ห่วงเขี่ยเชื้อ (loop) แตะตัวอย่างหรือสิ่งส่งตรวจแล้วลากหรือขีด (streak) ลงบนจานเพาะเชื้อที่มีอาหารแข็ง (agar plate) อยู่ให้ได้แนวระนาบติดต่อกัน 4-5 เส้น หลังจากเสร็จในระนาบแรกซึ่งมีเชื้อจุลินทรีย์อยู่หนาแน่นที่สุด ให้นำห่วงเขี่ยเชื้อมาเผาไฟให้ลวดที่ปลายร้อนแดงเพื่อฆ่าเชื้อที่ติดให้หมด จากนั้นจึงขีดเชื้อจากส่วนของรอยลากในระนาบแรกออกมาเพียงหนึ่งครั้งแล้วลากเป็นระนาบที่สอง 4-5 เส้นติดกันโดยรอยขีดของเชื้อจะไม่ทับกับระนาบแรกอีก หลังจากนั้นก็ทำเช่นเดียวกันกับระนาบที่สองจนครบทั่วทั้งจานเพาะเชื้อซึ่งมีประมาณสี่ระนาบ (ภาพที่ 1-2) เมื่อได้เชื้อบริสุทธิ์แล้วจะมีการศึกษาเชื้อต่อไปในด้านต่างๆ ซึ่งจะต้องมีการถ่ายเชื้อจากอาหารเดิมไปยังอาหารใหม่ หรือมีการเพาะเชื้อลงในอาหารเพื่อการทดสอบและการวิเคราะห์ต่างๆ ดังนั้นการเรียนรู้เทคนิคที่ถูกต้องในการถ่ายเชื้อจึงมีความสำคัญเป็นอย่างยิ่งซึ่งต้องอาศัยหลักการของ aseptic technique เพื่อป้องกันการปนเปื้อนของเชื้อชนิดอื่นซึ่งจะทำให้ผลการทดลองผิดพลาดได้ อุปกรณ์พื้นฐานที่ใช้ในการถ่ายเชื้อคือ ห่วงเขี่ยเชื้อ เข็มเขี่ยเชื้อ (needle) และตะเกียงอัลกอฮอล์สำหรับใช้ฆ่าเชื้อโดยการเผา (incineration) การถ่ายเชื้อจุลินทรีย์พวกแบคทีเรียและยีสต์จะใช้ห่วงเขี่ยเชื้อเป็นส่วนใหญ่ มีบางครั้งที่ใช้เข็มเขียเชื้อปลายตรง ส่วนเชื้อราที่เป็นเส้นสาย (filamentous fungi) มักจะใช้เข็มเขี่ยปลายงอ

ภาพที่ 1-2 การแยกเชื้อด้วยวิธี cross streak plate
3. วัตถุประสงค์
1. เพื่อให้นักศึกษาเทคนิคพื้นฐานเกี่ยวกับทางจุลชีววิทยาได้แก่ การถ่ายเชื้อที่ถูกต้องด้วยเทคนิคปลอดเชื้อ (aseptic technique) การทำ serial dilution, Spread plate, Pour plate และ Streak plate
2. เพื่อให้นักศึกษาเรียนรู้และเข้าใจเกี่ยวกับข้อควรระวังและความปลอดภัยในการการปฏิบัติงาน
4. วิธีการทดลอง
4.1 การเพาะเชื้อแบบ Spread Plate
การเจือจางแบบ 10 serial dilutions
- ปิเปต 1 ml ซัสเพนชันของเชื้อตั้งต้น (100) มาใส่หลอดที่มีน้ำเกลือ (0.9 % NaCl) ที่ฆ่าเชื้อแล้ว ปริมาตร 9 ml ด้วยเทคนิคปลอดเชื้อ เขย่าให้เข้ากัน จะได้เป็นซัสเพนชันของเชื้อที่ 10-1
- ปิเปตซัสเพนชันของเชื้อที่ได้ (10-1) 1 ml ใส่หลอดที่มีน้ำเกลือ (0.9 % NaCl) ที่ฆ่าเชื้อแล้ว ปริมาตร 9 ml ด้วยเทคนิคปลอดเชื้อ เขย่าให้เข้ากัน จะได้เป็นซัสเพนชันของเชื้อที่ 10-2
- ปิเปตซัสเพนชันของเชื้อที่ได้ (10-2) 1 ml ใส่หลอดที่มีน้ำเกลือ (0.9 % NaCl) ที่ฆ่าเชื้อแล้ว ปริมาตร 9 ml ด้วยเทคนิคปลอดเชื้อ เขย่าให้เข้ากัน จะได้เป็นซัสเพนชันของเชื้อที่ 10-3
- นำไปทดลองต่อในขั้นต่อไป : การเพาะเชื้อแบบ Spread Plate และ Pour Plate
ภาพที่ 1-3 ขั้นตอนการทำ serial dilution
ที่มา: Prescott (2002)
ขั้นตอนการ Spread plate
1. ระบุชื่อ-กุล นักศึกษา วันที่ทำการทดลองที่ด้านล่างของจานเพาะเชื้อ
2. ปิเปตตัวอย่างปริมาตร 0.1 มิลลิลิตร ลงที่ตำแหน่งตรงกลางจานเพาะเชื้อ
3. จุ่มแท่งแก้วรูปตัวแอล (spreader) ในแอลกอฮอล์เข้มข้นร้อยละ 95 แล้วเอียง spreader ที่ขอบของบีกเกอร์เพื่อแยกแอลกอฮอล์ส่วนเกินออก
4. นำแท่งแก้วเกลี่ย spreader ที่ผ่านการจุ่มแอลกอฮอล์ไปเผาไฟจนแอลกอฮอล์ไหม้หมด และปล่อยให้ spreader เย็น
5. นำ spreader เกลี่ยเชื้อให้ทั่วจานจานเพาะเชื้อ และระมัดระวังไม่ให้มือสัมผัสกับขอบด้านในของจานเพาะเชื้อ
6. จุ่ม spreader ในแอลกอฮอล์เข้มข้นร้อยละ 95 และกำจัดแอลกอฮอล์ส่วนเกินโดยให้แท่งแก้วสัมผัสกับของบีกเกอร์ นำเผาไฟจนแอลกอฮอล์ไหม้หมด ปล่อยให้เย็น และนำไปเกลี่ยเชื้อแบคทีเรียจานในจานเพาะเชื้อที่เหลือ โดยขั้นตอนการ Spread plate แสดงไว้ในภาพที่ 1-4
7. กลับจานเพาะเชื้อให้ด้านที่มีอาหารเพาะเชื้ออยู่ด้านบน แล้วนำไปบ่มที่อุณหภูมิ 37 องศาเซลเซียส นาน 24-48 ชั่วโมง
8. สังเกตลักษณะของโคโลนีที่ปรากฏ
ภาพที่ 1-4 ขั้นตอนเพาะเชื้อด้วยเทคนิค spread plate technique
ที่มา: Prescott (2002)
4.2 การเพาะเชื้อแบบ Pour Plate
- เตรียมจานเพาะเชื้อ (เปล่า) เขียนชื่อ-สกุล วันที่ทำการทดลองที่ด้านล่างของจานเพาะเชื้อ
- เตรียมหลอดอาหาร NA ปริมาตร 15 ml ที่ผ่านการฆ่าเชื้อแล้ว
- เตรียมปิเปตขนาด 1 ml ที่ผ่านการฆ่าเชื้อแล้ว
- ปิเปตซัสเพนชันของเชื้อที่อัตราการเจือจาง 10-1 ปริมาตร 1.0 ml ปล่อยลงในจานเพาะเชื้อด้วยเทคนิคปลอดเชื้อ
- เทอาหารจากหลอดอาหาร NA 15 ml ลงในจานเพาะเชื้อที่มีเชื้ออยู่แล้ว
- หมุนจานเพาะเชื้อเพื่อให้เชื้อและอาหารผสมเข้ากันดี รอจนอาหารกลายเป็นวุ้นแข็งดีแล้วจึงคว่ำจานเพาะเชื้อ แล้วนำไปบ่มที่ 3737oC 24-48 ชั่วโมง ทำซ้ำโดยใช้ซัสเพนชันของเชื้อที่ 10-2 แทน โดยขั้นตอนการ pour plate แสดงไว้ในภาพที่ 1-5
ภาพที่ 1-5 ขั้นตอนการเพาะเชื้อด้วยเทคนิค pour plate
ที่มา: Prescott (2002)
4.3 การทำให้เชื้อบริสุทธิ์ด้วยเทคนิค Streak plate
1. ระบุชื่อ-กุล นักศึกษา วันที่ทำการทดลองที่ด้านล่างของจานเพาะเชื้อที่มีอาหารเลี้ยงอยู่
2. ใช้ลูบเขี่ยเชื้อ (Loop) เขี่ยเอาเชื้อออกจากหลอดที่มีเชื้อด้วยเทคนิคปลอดเชื้อ (Aseptic technique) ดังแสดงในภาพที่ 1-6
ภาพที่ 1-6 การถ่ายเชื้อด้วยเทคนิคปลอดเชื้อ
ที่มา: Prescott (2002)
3. แล้วทำการ Streak เชื้อที่อยู่ปลาย loop ลงบนจานเพาะเชื้อที่มีอาหารเลี้ยงเชื้อที่ได้เตรียมไว้แล้ว ด้วยความระมัดระวัง ซึ่งมีขั้นตอนดังนี้
3.1 เปิดฝาจานเพาะเชื้อให้มีช่องว่างเพียงพอที่จะสอด loop เข้าไปได้ง่าย ดังแสดงในภาพที่ 1-7 (ก) แล้วสอด Loop ที่มีเชื้อแบคทีเรียอยู่ทำการ streak ที่พื้นที่หมายเลข 1 โดยในระหว่างการ streak จะต้องไม่ทำให้ผิวของอาหารแตก
3.2 เมื่อ streak ที่บริเวณพื้นที่หมายเลข 1 แล้วให้นำ Loop ออกมาฆ่าเชื้อโดยการเผาไฟ หลังจากนั้นทำให้ loop เย็นลงโดยการแตะที่ขอบของอาหารเลี้ยงเชื้อใกล้ๆ กับบริเวณหมายเลข 1
3.3 หมุนจานเพาะเชื้อให้อยู่ในตำแหน่งที่เหมาะสมสำหรับการ streak บริเวณพื้นที่หมายเลข 2 แล้วทำการ cross streak โดยจุดเริ่มต้นจะอยู่ที่บริเวณพื้นที่หมายเลข 1 แล้วทำการ Streak ที่บริเวณพื้นที่หมายเลข 2 ดังภาพที่ 1-7 (ข)
3.4 เมื่อ streak ที่บริเวณพื้นที่หมายเลข 2 แล้วให้นำ Loop ออกมาฆ่าเชื้อโดยการเผาไฟ หลังจากนั้นทำให้ loop เย็นลงโดยการแตะที่ขอบของอาหารเลี้ยงเชื้อใกล้ๆ กับบริเวณหมายเลข 2
3.5 หมุนจานเพาะเชื้อให้อยู่ในตำแหน่งที่เหมาะสมสำหรับการ streak บริเวณพื้นที่หมายเลข 3 แล้วทำการ cross streak โดยจุดเริ่มต้นจะอยู่ที่บริเวณพื้นที่หมายเลข 2 แล้วทำการ Streak ที่บริเวณพื้นที่หมายเลข 3 ดังภาพที่ 1-7 (ข) ถ้าหากจำเป็นสามารถทำการ streak ที่บริเวณพื้นที่หมายเลข 4 ได้
3.6 กลับจานเพาะเชื้อแล้วนำไปบ่มในตู้บ่มเชื้อควบคุมอุณหภูมิ 37 องศาเซลเซียส นาน 24-48 ชั่วโมง แล้วสังเกตการเจริญของเชื้อ
ภาพที่ 1-7 ขั้นตอนการทำเชื้อบริสุทธิ์ด้วยเทคนิค Streak plate
ที่มา: Prescott (2002)